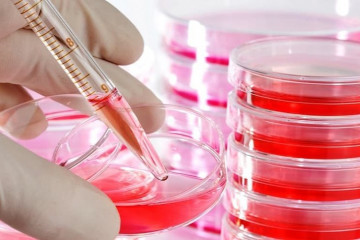

-
سرپرست مرکز روابط عمومی و اطلاع رسانی وزارت بهداشت با انتشار توییتی از پیگیری موضوع فروش کارت بدون انجام واکسیناسیون توسط نهادهای امنیتی خبر داد.
۲۰ دی ۱۴۰۰ - ۱۳:۰۲ -
مدیرکل دفتر بهبود تغذیه جامعه وزارت بهداشت گفت: بیماریهای غیرواگیر علت ۶۰ درصد مرگها در جهان و ۷۶ درصد مرگ ها در ایران است. این وضعیت در تمام کشورهای با درآمد بالا، متوسط و پایین از جمله در ایران که درآمد متوسط دارد، یک روند افزایشی دارد، ۱۰ عامل از ۱۹ عامل مرگ در بیماریهای غیرواگیر مربوط به تغذیه است.
۲۰ دی ۱۴۰۰ - ۱۲:۳۶ -
مجموع مبتلایان به بیماری "کووید-۱۹" در جهان تاکنون به ۳۰۷ میلیون و ۹۰۷ هزار و ۹۲۶ نفر رسیده، مرگ پنج میلیون و ۵۰۶ هزار و ۵۵ نفر بر اثر این بیماری تایید شده است و ۲۵۹ میلیون و ۵۸۳ هزار و ۷۲۴ نفر از مبتلایان نیز تاکنون بهبود یافتهاند.
۲۰ دی ۱۴۰۰ - ۱۲:۰۰ -
وزیر بهداشت، درمان و آموزش پزشکی در حکمی کورش ساکی را به عنوان سرپرست دانشگاه علوم پزشکی و خدمات بهداشتی درمانی کاشان منصوب کرد.
۲۰ دی ۱۴۰۰ - ۱۱:۳۳ -
دبیر کمیته تخصصی تشخیص و درمان کووید با تاکید بر اقدامات پیشگیرانه نسبت به اقدامات درمانی گفت: هم اکنون باید از ایجاد موج جدید پیشگیری کنیم چون اگر موج اُمیکرون به وجود بیاید، اقدامات بعدی موفقیت آمیز نخواهد بود، خطر پیک جدید بواسطه حضور سویه اُمیکرون به شدت تهدیدکننده است، این سویه سرایت پذیری بالا و گردش زیادی دارد و می تواند تعداد مبتلایان را به صورت تصاعدی افزایش دهد.
۲۰ دی ۱۴۰۰ - ۱۱:۰۰ -
عفونت با سویه اُمیکرون کروناویروس علائمی ایجاد میکند که بسیار شبیه به سرماخوردگی است اما متخصصان سلامت اکنون نسبت به علائم غیرمعمول عفونت با این سویه هشدار میدهند که میتواند روی پوست، لبها یا ناخنهای شما تاثیر بگذارد.
۲۰ دی ۱۴۰۰ - ۱۰:۱۰ -
دیوان عدالت اداری برگزاری آزمون دستیاری در اسفند ۱۴۰۰ را لغو کرد، اما هنوز تاریخ دقیق برگزاری آزمون اعلام نشده است.
۲۰ دی ۱۴۰۰ - ۰۹:۳۰ -
سخنگوی پروژه واکسن کووپارس موسسه تحقیقات واکسن و سرم سازی رازی ضمن تشریح آخرین اخبار پیرامون کارآزمایی بالینی واکسن کووپارس و تولید آن گفت: تاکنون حدود ۱۰ میلیون دز واکسن تولید کردیم و وزارت بهداشت به ما قول داده است ۵ میلیون دز را تحویل بگیرد؛ البته هنوز این اتفاق نیفتاده است.
۲۰ دی ۱۴۰۰ - ۰۹:۰۱ -
عضو کمیسیون بهداشت و درمان مجلس گفت: امروز خبری به نقل از بنده در خصوص اعلام وصول طرح استیضاح وزیر بهداشت به هیات رییسه منتشر شده که کاملا نادرست است و بنده چنین اظهاراتی نداشته ام.
۱۹ دی ۱۴۰۰ - ۱۷:۳۰ -
وزیر بهداشت، درمان و آموزش پزشکی گفت: پزشکی قانونی ایران، پزشکی قانونی برتر منطقه است و باید این موضوع را در قالب ارتباطات قویتر با کشورهای منطقه به دنیا نشان دهیم زیرا نتایج آن به نفع کشور و نظام خواهد بود.
۱۹ دی ۱۴۰۰ - ۱۷:۰۰ -
عضو کمیته علمی کشوری مقابله با کرونا با بیان اینکه شمار آزمایش های مثبت اومیکرون رو به افزایش است گفت: در سه هفته اخیر درصد موارد آزمایش مثبت اومیکرون در کشور از ۸.۷ درصد به ۲۷.۷۳ درصد از نمونه های ارسالی رسیده است.
۱۹ دی ۱۴۰۰ - ۱۶:۳۱ -
رئیس انستیتو پاستور ایران در پاسخ به اینکه کدام واکسن برای تزریق به کودکان ۵ تا ۱۱ سال علیه کرونا مجوز دریافت میکند گفت: قطعا واکسن پاستاکووک برای سنین ۵ تا ۱۱ سال تصویب خواهد شد و احتمال میدهیم که حداکثر تا پایان این ماه تصمیمات لازم در اینخصوص اتخاذ شود.
۱۹ دی ۱۴۰۰ - ۱۶:۰۱ -
رئیس پژوهشگاه رویان گفت: خوشبختانه ایران در حوزه سلول های بنیادی گام های مطلوب و مثبتی را برداشته است و در باب سلول های بنیادی در میان کشورهای منطقه رتبه نخست را دارد.
۱۹ دی ۱۴۰۰ - ۱۵:۲۰ -
بنابراعلام وزارت بهداشت از دیروز تا امروز ۱۹ دی ماه ۱۴۰۰ و بر اساس معیارهای قطعی تشخیصی، یک هزار و ۴۸۰ بیمار جدید مبتلا به کووید۱۹ در کشور شناسایی شد که ۲۲۶ نفر از آنها بستری شدند، مجموع بیماران کووید۱۹ در کشور به ۶ میلیون و ۲۰۶ هزار و ۴۰۵ نفر رسید، متاسفانه در طول ۲۴ ساعت گذشته، ۳۱ بیمار کووید۱۹ جان خود را از دست دادند و مجموع جان باختگان این بیماری به ۱۳۱ هزار و ۸۷۸ نفر رسید.
۱۹ دی ۱۴۰۰ - ۱۴:۴۸ -
عضو کمیته علمی کشوری مبارزه با کرونا با هشدار نسبت به روند افزایشی سویه امیکرون کرونا در کشور و اهمیت تزریق دز سوم واکسن گفت: لازم است فاصله بین دز دوم و سوم واکسن را کاهش دهیم و به یک ماه برسانیم تا افراد زودتر بتوانند دز سوم را تزریق کنند زیرا شاید فرصتی تا موج امیکرون نداشته باشیم.
۱۹ دی ۱۴۰۰ - ۱۴:۳۲
پربینندهترینها
پربحثترینها
شبکههای اجتماعی